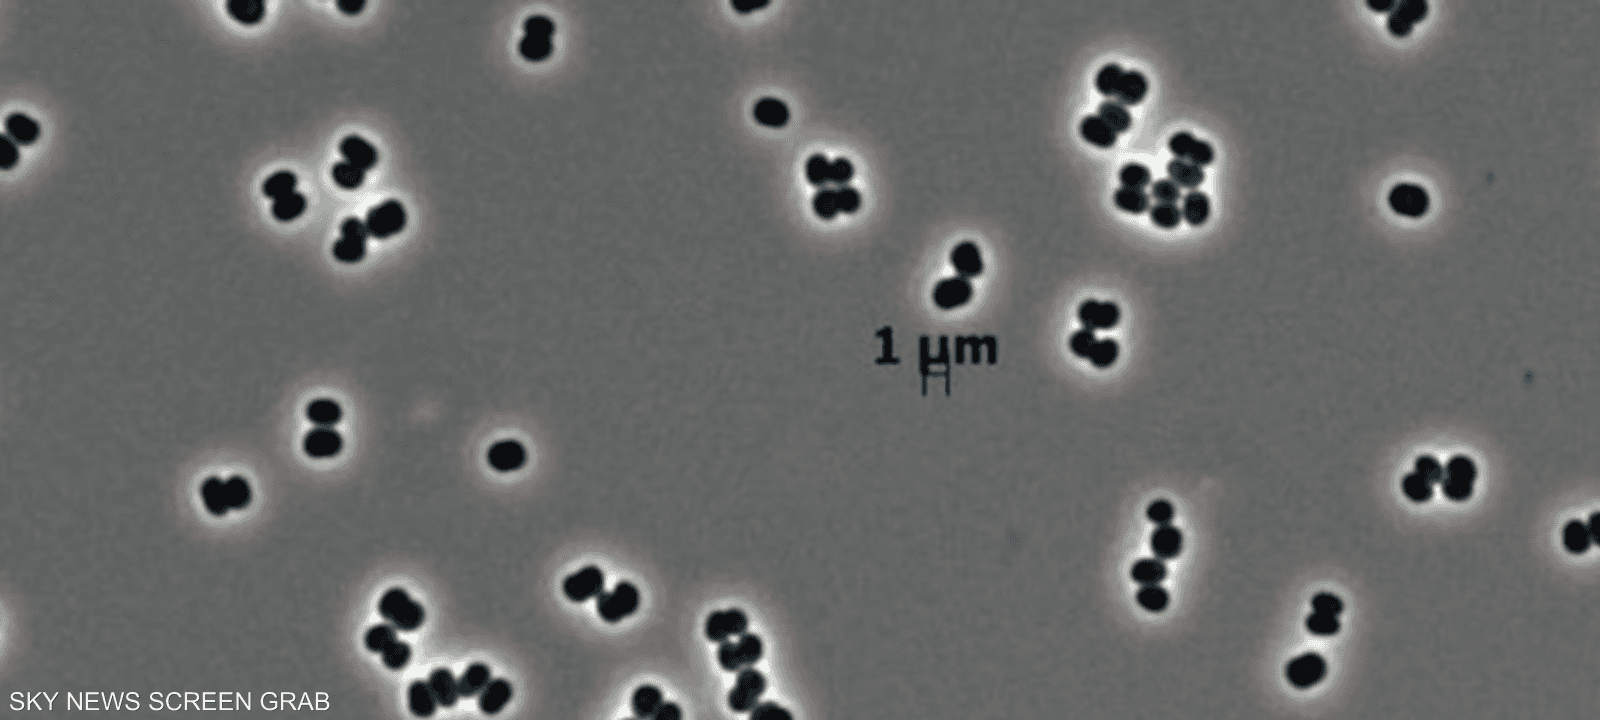
البكتيريا تتظاهر بالموت

حتى في بيئة معقمة.. اكتشاف بكتيريا قادرة على التظاهر بالموت
15:33 - 04 ديسمبر 2025
كشفت دراسة حديثة أن وكالة "ناسا" عثرت على نوع بكتيري نادر يمتلك قدرة فريدة على الدخول في حالة خمول عميقة تجعله غير قابل للكشف تقريباً، ما يثير احتمالاً بأن يكون قد انتقل بالصدفة إلى المريخ على متن مركبات فضائية.
بكتيريا ظهرت في أكثر الأماكن تعقيماً
البكتيريا الجديدة، التي أُطلق عليها Tersicoccus phoenicis، اكتُشفت قبل نحو عقد داخل غرف التعقيم الخاصة بتجميع المركبات الفضائية في ناسا ووكالة الفضاء الأوروبية، رغم أن هذه الغرف تُعدّ من أنظف البيئات على سطح الأرض والمخصصة لمنع انتقال أي ميكروبات إلى الكواكب الأخرى.
ورغم أنها غير مؤذية، فإن قدرتها على النجاة في أقسى الظروف أثارت قلق العلماء، خاصة بعد تكرار ظهورها في منشأتين تفصل بينهما آلاف الكيلومترات.
الدراسة كشفت أن هذه البكتيريا قادرة على الدخول في سبات شبه كامل يمنع العلماء من رصدها أو تنميتها مخبرياً.
يقول الباحث مادان تيرومالاي: "إنها لا تموت.. كانت فقط تتظاهر بالموت".
وتبيّن أن البكتيريا تحمل جيناً يسمح لها بإعادة تنشيط نفسها عند توفر ظروف معينة، وهو ما يسهم في قدرتها على البقاء مختبئة لفترات طويلة.
تهديد لبرامج حماية الكواكب
ظهور هذه البكتيريا يفتح الباب أمام احتمالات أن تكون ميكروبات مشابهة قد نجحت في شق طريقها إلى مركبات فضائية انطلقت بالفعل إلى المريخ أو أماكن أخرى، رغم البروتوكولات الصارمة لتنظيف المركبات.
ويقول باحثون إن المشكلة لا تقتصر على استكشاف الكواكب، بل تمتد إلى القطاعات التي تعتمد غرفاً معقمة مثل الصناعات الدوائية والزراعية والمستشفيات، حيث يمكن لميكروبات "مختبئة" أن تفلت من الفحوصات التقليدية.
لماذا هو اكتشاف مقلق؟
- يمكن للبكتيريا أن تبقى خاملة حتى بعد تزويدها بالمواد الغذائية.
- قد تعود للحياة عند ملامستها بكتيريا أخرى تفرز بروتينات معيّنة.
- قد تعيش لسنوات في بيئات جافة ومعقمة تماماً.
- الدفاعات المناعية للبشر تضعف في الفضاء، ما قد يجعلها أكثر خطراً على رواد الفضاء.
هل وصلت فعلاً إلى المريخ؟
يرى العلماء أن احتمال نجاة هذه البكتيريا في الفضاء ضعيف، لكن غير مستبعد، ما يستدعي تشديد الرقابة على غرف تصنيع المركبات واستخدام تقنيات جديدة للبحث عن الميكروبات "النائمة".




